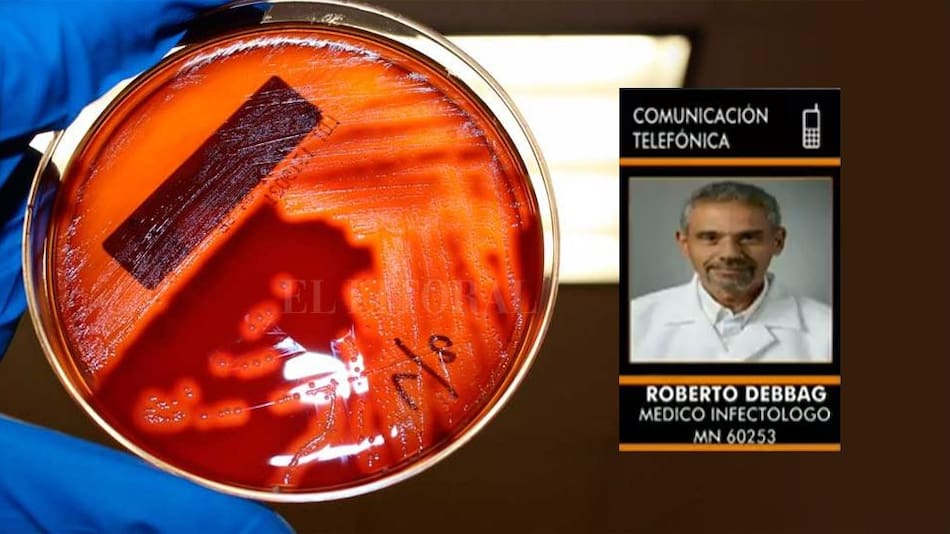
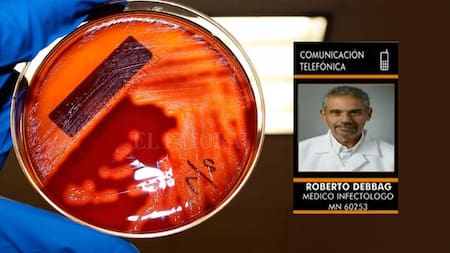
Estreptococo - Radio Latina

Alerta estreptococo: "Hay que consultar rápido cuando un niño tiene fiebre o angina"
En plena psicosis activada por la aparición de la bacteria del estreptococo pyogene, que llevó a la muerte 6 personas (5 niños y un adulto) durante las últimas horas en diferentes lugares de la Argentina, este miércoles Paulinio Rodrígues habló en entrevista exclusiva en su programa "En formato Paulino" por Radio Latina 101.1, con el doctor Roberto Debbag, médico infectólogo.
"Este estreptococo es el que los padres y médicos saben que durante los meses de primavera producen anginas", comenzó diciendo el médico. Y agregó: "Esto, con medicamentos muy simples se cura y en unas pocas horas el paciente ya empieza a estar mejor. Peo lo que ocurre sólo en muy pocos casos, muy extrañamente, esa bacteria produzca una enfermedad grave que puede llevar a la muerte".
Puntualmente sobre los seis casos mortales conocidos hasta este miércoles, dijo Debbag que "no se puede decir hasta este momento, en estos casos, cuáles fueron los factores que han favorecido esto, pero sí lo que se sabe es que todos los estreptococos no son iguales. Algunos tienen mayor probabilidad de producir una toxina que produce esta enfermedad", aseguró.
"Los niños que tienen estas enfermedades virales, como varicela o gripe, se predisponen a este tipo de infección grave", afirmó el médico. Y continuó: "Lo que pasó en Argentina es que el brote epidémico anual se dio en agosto / septiembre en lugar de darse en junio / julio, pero de todos modos creemos que es una infección que va a provocar un brote epidémico porque las víctimas son de diferentes lugares".
También podría interesarte
Luego dijo Debbag: "La precaución que hay que tener es la de consultar rápidamente cuando un niño tenga fiebre o angina, para hacerle los estudios necesarios en tiempo y forma. Si es un estreptococo se le da antibiótico y se cura de inmediato".
"Hoy, el estreptococo es 100% sensible a la penicilina, de modo que con un diagnóstico rápido en 48 hs. el paciente ya siente mejoría", concluyó el doctor Roberto Debbag.